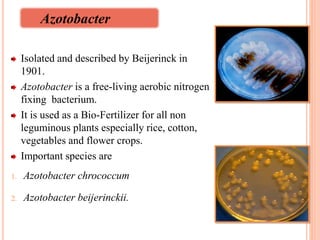
Isolated and described by Beijerinck in
1901.
Azotobacter is a free-living aerobic nitrogen
fixing bacterium.
It is used as a Bio-Fertilizer for all non
leguminous plants especially rice, cotton,
vegetables and flower crops.
Important species are
1. Azotobacter chrococcum
2. Azotobacter beijerinckii.
14
Azotobacter

This document provides an overview of a seminar on bio-inoculants and their utility in commercial flower production. It begins with an introduction to the topic and an outline of what will be covered. It then discusses the types of bio-inoculants including rhizobium, azotobacter, azospirillum, phosphate solubilizing microorganisms, vesicular arbuscular mycorrhizae, and their roles and benefits. Several studies on the effects of various bio-inoculants on the growth and yield of different flower crops are summarized. The document concludes with tables showing biofertilizer production data in India from 2011-2015.